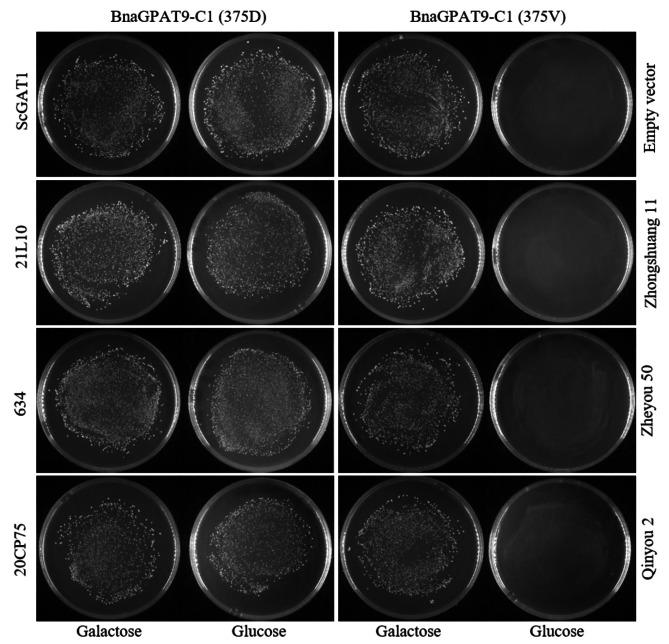

同源 GPAT9 基因的功能分化导致油菜籽中芥酸含量的不同。
The functional divergence of homologous GPAT9 genes contributes to the erucic acid content of Brassica napus seeds.
机构信息
The Key Laboratory for Quality Improvement of Agricultural Products of Zhejiang Province, College of Advanced Agricultural Sciences, Zhejiang A & F University, Hangzhou, 311300, China.
Institute of Crop Science and Zhejiang Key Laboratory of Crop Germplasm, Zhejiang University, Hangzhou, 310058, China.
出版信息
BMC Plant Biol. 2024 Jan 24;24(1):69. doi: 10.1186/s12870-024-04734-0.
BACKGROUND
The early allopolyploid Brassica napus was a hybrid of two Brassica species, that had undergone a whole genome duplication event followed by genome restructuring, including deletions and small scale duplications. A large number of homologous genes appeared functional divergence during species domestication. Due to the high conservation of de novo glycerolipid biosynthesis, multiple homologues of glycerol-3-phosphate acyltransferases (GPATs) have been found in B. napus. Moreover, the functional variances among these homologous GPAT-encoding genes are unclear.
RESULTS
In this study, four B. napus homologous genes encoding glycerol-3-phosphate acyltransferase 9 (BnaGPAT9) were characterized. Although a bioinformatics analysis indicated high protein sequence similarity, the homologues demonstrated tissue-specific expression patterns and functional divergence. Yeast genetic complementation assays revealed that BnaGPAT9-A1/C1 homologues but not BnaGPAT9-A10/C9 homologues encoded functional GPAT enzymes. Furthermore, a single nucleotide polymorphism of BnaGPAT9-C1 that occurred during the domestication process was associated with enzyme activity and contributed to the fatty acid composition. The seed-specific expression of BnGPAT9-C1 increased the erucic acid content in the transformant seeds.
CONCLUSIONS
This study revealed that BnaGPAT9 gene homologues evolved into functionally divergent forms with important roles in erucic acid biosynthesis.
背景
早期的异源多倍体甘蓝型油菜是两种芸薹属物种的杂种,经历了全基因组复制事件,随后发生了基因组重排,包括缺失和小规模的重复。在物种驯化过程中,大量同源基因出现了功能分化。由于从头甘油磷脂生物合成具有高度保守性,在甘蓝型油菜中发现了多个甘油-3-磷酸酰基转移酶(GPAT)的同源物。此外,这些同源 GPAT 编码基因之间的功能差异尚不清楚。
结果
本研究对 4 个编码甘油-3-磷酸酰基转移酶 9(BnaGPAT9)的甘蓝型油菜同源基因进行了研究。尽管生物信息学分析表明这些蛋白具有高度的序列相似性,但这些同源物表现出组织特异性表达模式和功能分化。酵母遗传互补实验表明,BnaGPAT9-A1/C1 同源物而不是 BnaGPAT9-A10/C9 同源物编码具有功能的 GPAT 酶。此外,在驯化过程中发生的 BnaGPAT9-C1 单核苷酸多态性与酶活性相关,对脂肪酸组成有贡献。BnGPAT9-C1 的种子特异性表达增加了转化种子中的芥酸含量。
结论
本研究表明,BnaGPAT9 基因同源物进化为具有功能分化的形式,在芥酸生物合成中发挥重要作用。